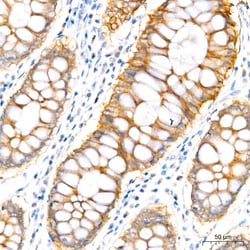
Invitrogen PER1 Recombinant Rabbit Monoclonal Antibody (2Y1M7) 20 &mu;L;
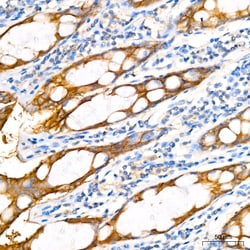
Invitrogen PER1 Recombinant Rabbit Monoclonal Antibody (2Y1M7) 20 &mu;L;

missing translation for 'onlineSavingsMsg'
Learn More
Learn More
Invitrogen™ PER1 Recombinant Rabbit Monoclonal Antibody (2Y1M7)
Rabbit Recombinant Monoclonal Antibody
Brand: Invitrogen™ MA558131
This item is not returnable.
View return policy
Description
Immunogen sequence: MSGPLEGADG GGDPRPGESF CPGGVPSPGP PQHRPCPGPS LADDTDANSN GSSGNESNGH ESRGASQRSS HSSSSGNGKD SALLETTESS KSTNSQSPSP PSSSIAYSLL SASSEQDNPS TSGCSSEQSA RARTQKELMT ALRELKLRLP PERRGKGRSG TLATLQYALA CVKQVQANQE YYQQWSLEEG EPCSMDMSTY.
Circadian rhythmicity is a basic property of phylogenetically diverse organisms which range from animals and plants, to fungi. Regulation of endogenous biological clocks is regulated at the genetic level by a protein-mediated, autoregulatory feed-back loop. In mammals, several genes that encode members of the basic helix-loop helix (bHLH) PAS (PER-ARNT-SIM) transcription factor family have been shown to play a significant role in regulating circadian oscillations. Transactivation of CLOCK-induced genes is mediated via an E box enhancer (CACGTG) found upstream of target genes. CLOCK-ARNT3 heterodimers bind to E box regulatory elements and stimulate gene transcription. CLOCK has been shown to transactivate the mammalian homolog of Drosophila per. PER, in concert with the product of the mammalian timeless gene (TIM), negatively regulates its own transcription by blocking the activity of the CLOCK-BMAL1 transactivation complex.
Specifications
| PER1 | |
| Recombinant Monoclonal | |
| 1.28 mg/mL | |
| PBS with 0.05% BSA, 50% glycerol and 0.09% sodium azide; pH 7.3 | |
| O15534, O35973 | |
| PER1 | |
| Recombinant fusion protein containing a sequence corresponding to amino acids 1-200 of human PER1 (NP_002607.2). | |
| 20 μL | |
| Primary | |
| Human, Mouse | |
| Antibody | |
| IgG |
| ELISA, Immunohistochemistry (Paraffin) | |
| 2Y1M7 | |
| Unconjugated | |
| PER1 | |
| circadian clock protein PERIOD 1; Circadian pacemaker protein Rigui; hPER; hPER1; KIAA0482; mPer1; m-rigui; PER; PER1; per1 {ECO:0000312; period 1; period circadian clock 1; period circadian protein homolog 1; period homolog 1; Period, drosophila, homolog of; RGD:727863}; RIGUI; rPER1 | |
| Rabbit | |
| Protein A | |
| RUO | |
| 18626, 5187 | |
| -20°C, Avoid Freeze/Thaw Cycles | |
| Liquid |
Product Content Correction
Your input is important to us. Please complete this form to provide feedback related to the content on this product.
Product Title
Spot an opportunity for improvement?Share a Content Correction